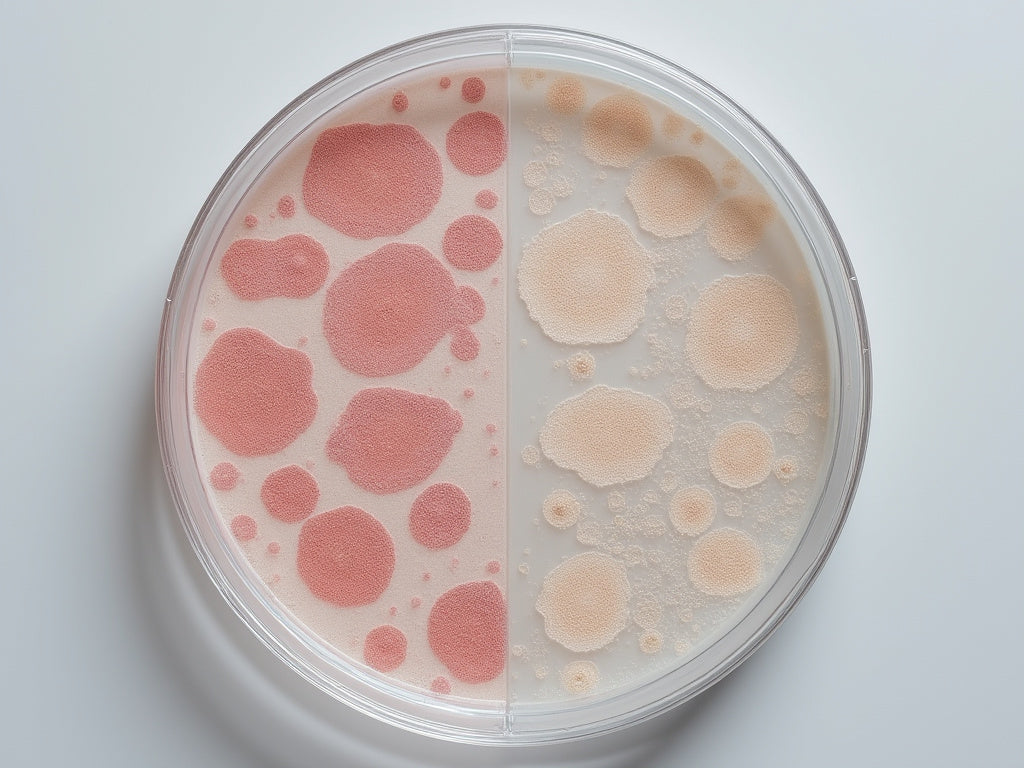

ISCA Cosmetic Testing
Balance Testing
Balance Testing
The skin microbiome is a complex and quickly evolving area of cosmetic science. How cosmetic products interact with the microbiome can have an important effect on our skin health. ISCA Cosmetic Testing are developing a series of tests that will give an indication of the effect your cosmetic formulation has on the skin balance between 2 bacterial cultures.
The microbiome balance test assesses whether a cosmetic product has the potential to alter the balance of ‘skin friendly’ bacteria, such as Staphylococcus epidermidis , in favour of pathogenic species such as Staphylococcus aureus.
This bacterial balance plays a crucial role in our skin’s health, since a change in bacterial composition has been linked to conditions such as eczema, rosacea, acne and psoriasis.
To carry out the test we would require 250g/ml of the product.
E.g. Batch number, formulation number etc. This is to allow us to uniquely identify your sample in our laboratory.
This should correspond to the label on your sample.
Impossibile caricare la disponibilità di ritiro
Prices listed are for 1 test programme on 1 sample.
For more information about sending your samples, please see our FAQ below.
Visualizza dettagli completi
Sending Samples
FAQ
Quantity to send
We will need a minimum of 250 ml of your sample for Viscosity or pH testing.
Where to send
Please send 250 g of each sample to our laboratory address,
ISCA Cosmetic Testing
Unit 28 Nine mile point ind. est.
Crosskeys,
Newport, UK
NP11 7HZ
Packaging
Samples should be sent in their final retail packaging where possible.
Sample labelling
Please label your samples clearly (including unique ID numbers) and ensure that you keep a record yourself of what samples you have sent us to avoid any confusion. What you label your sample is what will be recorded on your final report.